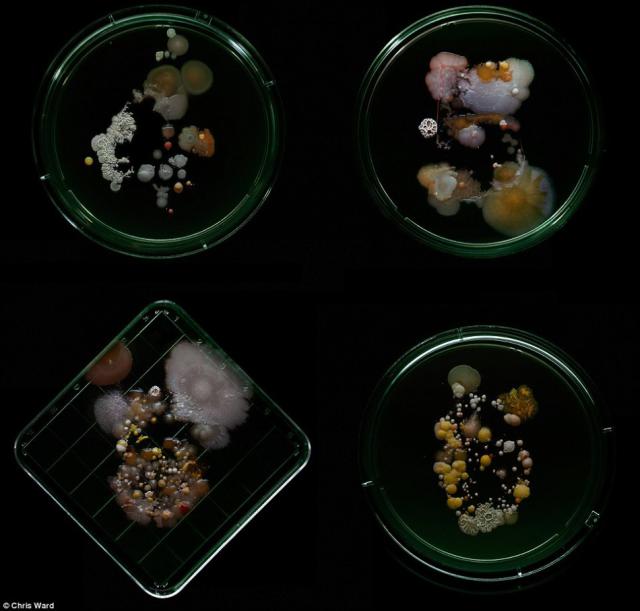
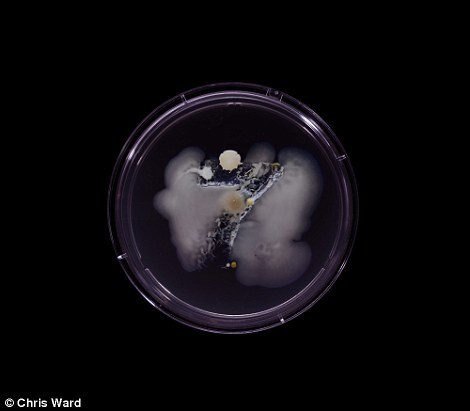

北京时间12月7日消息,从纽约地铁4号、5号、6号线和6号快线上采集的微生物培养结果,有的还包含无乳链球菌。克雷格・沃德是一位插画师和艺术家,在名为“看不见的地铁系列”的艺术项目中,他将科学与艺术结合了起来。

沃德用海绵采集地铁列车上的细菌。

沃德从纽约地铁L线开始采集细菌。

S线地铁上的细菌,包括大肠杆菌、沙门氏菌和金黄色葡萄球菌。这些细菌在培养皿里增殖,并组成了地铁线路代号的形状。

L线地铁上的细菌,包括大肠杆菌、奇异变形杆菌、藤黄微球菌、枯草芽孢杆菌和粘质沙雷氏菌。

“这个项目的成功让我非常兴奋,”沃德说,“我曾想过这是个非常有趣的主意,但并不确定会得到什么结果。”

沃德说:“我从L线开始,而那里后来成为我的最爱。这里的细菌是最多样,色彩最丰富的。实话说,我真的非常高兴这个项目能成功。”

地铁N线、Q线和R线上的细菌。沃德发现了大量的病原体,包括大肠杆菌、沙门氏菌和葡萄球菌。

地铁Z线的细菌,包括普通变形杆菌,通常出现在粪便中。

地铁D线的细菌,包括大肠杆菌、金黄色葡萄球菌和霉菌。沃德说:“以平常的眼光看地铁,你会看到不同体型,不同体色的人,而当你从微生物的角度观察时,也会发现各种各样形状、大小和颜色的细菌群落。”

地铁G线的微生物,包括大肠杆菌、沙门氏菌、藤黄微球菌和枯草芽孢杆菌。沃德说:“这是在一个非常小的尺度上对这座城市进行刻画。”

地铁7号线上的微生物,包括金黄色葡萄球菌和藤黄微球菌。科学家和志愿者从2013年至今,已经在纽约地铁中发现了637种已知的细菌、病毒、真菌和动物。

2015年2月,康奈尔大学维尔医学院的科学家发表了他们进行了18个月的研究,他们在纽约地铁中发现了15152种不同类型的微生物(包括痢疾杆菌、脑膜炎细菌和引起腺鼠疫的耶尔森氏菌),它们每天与550万的乘客共享地铁列车。

首席研究员克里斯・梅森(Chris Mason)博士于近日发布了一张“病理学地图”(PathoMap),向我们展现了纽约城市地铁中微生物和DNA的分布情况。该项目利用一台超级计算机对超过100亿个生物医学片段进行了分析。

康奈尔大学维尔医学院的科学家对纽约地铁内的刷卡机、售票亭、扶手和长凳进行取样。图中红色显示的是细菌最多的区域,颜色较浅的地方则细菌较少。根据他们发表在Cell.com的研究结果,大部分细菌都是无害的,但接近一半(48%)的DNA都未能找到相吻合的已知生物体。

图中标出了纽约人流最多的几个地铁站,那里所发现的细菌数量也最多,因而一些细菌性疾病,如食物中毒等的风险也较大。在466个开放车站中,有一半都发现了与食物中毒等疾病有关的微生物。

纽约地铁素来以肮脏出名,但乘客或许直到现在才能直观感受到情况的严重程度。在纽约中部地区已经发现了炭疽菌和鼠疫菌。不过,科学家指出,这类危险的细菌并不多见,而且,综合纽约6个医学中心和世界其他机构的研究表明,这些病原体都已经失去活性。

位于纽约布鲁克林的G线美特尔-威洛比大道站(Myrtle-Willoughby)具有最多样的细菌种类,科学家发现了95种细菌。科学家称,大部分有害细菌的数量都很低,而有益细菌或中性细菌会在竞争中占据优势。另一方面,城市居民的免疫系统也足以应对这些日常的微生物。

研究者在12%的样品中,发现了67种与疾病有关的细菌。在总的DNA样品中,来自细菌的成分占约47%。在细菌之外,最常见的DNA来自昆虫、植物和人类自身,其中人类DNA占取样总量的0.2%。

克里斯・梅森博士称,有些人喜欢舔地铁扶手杆,但他们应该“没什么事”。图中是前纽约市市长迈克尔・布隆伯格。在上海、东京、巴黎和圣保罗等城市,科学家也在进行着类似的地铁研究。研究微生物在城市环境中的转移情况,将帮助他们追踪长期的健康趋势。(任天)